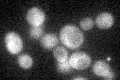
YAL017W
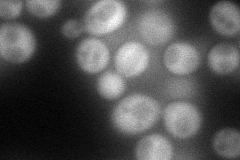
YAL017W
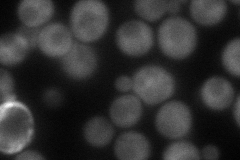
YAL017W
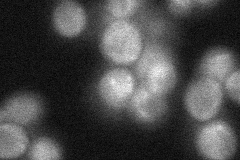
YAL017W
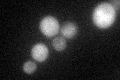
YAL017W
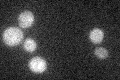
YAL017W

View description
One of two (see also PSK2) PAS domain containing S/T protein kinases; coordinately regulates protein synthesis and carbohydrate metabolism and storage in response to a unknown metabolite that reflects nutritional status
Localization:
Intensity:
Fold change:
Significance:
-
C’ GFP library in SD
cytosol25.2 -
N' NOP1pr-GFP in SD
cytosol74.8528 -
N' TEF2pr-mCherry in SD
cytosol78.4557 -
N' NATIVEpr-GFP in SD
cytosol,punctate29.5742 -
N' TEF2pr-VC and Cyto-VN in SD

#N/A0 -
C’ GFP library in SD+DTT
cytosol28.651.13No -
C’ GFP library in SD+H2O2

cytosol29.161.15No -
C’ GFP library in Starvation Media
cytosol25.891.02No -
C’ GFP library on the background of Pup2-DaMP

cytosol -
C’ GFP library on the background of CCT mutant

cytosol31.17581.23684No
